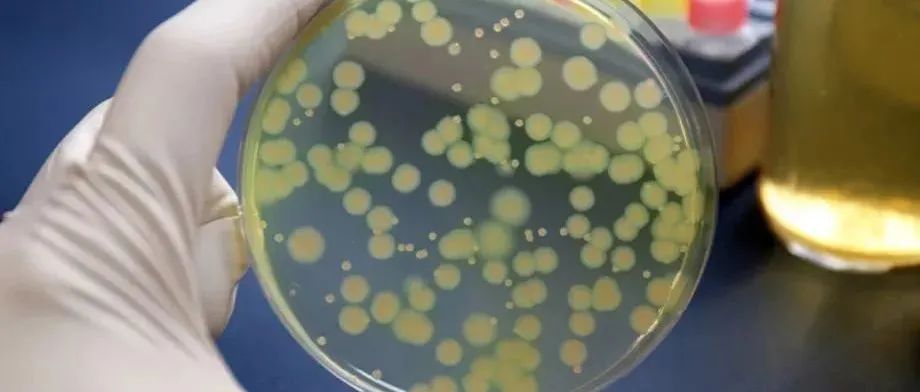

中国多黏菌素类抗菌药物临床合理应用多学科专家共识
作者:中国医药教育协会感染疾病专业委员会 中华医学会呼吸病学分会 中华医学会重症医学分会 中华医学会血液学分会 中华医学会细菌感染与耐药防治分会 中国药学会药物临床评价研究专业委员会 全球华人临床微生物与感染学会引用本文: 中国医药教育协会感染疾病专业委员会, 中华医学会呼吸病学分会, 中华医学会重症医学分会, 等. 中国多黏菌素类抗菌药物临床合理应用多学科专家共识 [J] . 中华结核和呼吸杂志, 2021, 44(4) : 292-310. DOI: 10.3760/cma.j.cn112147-20201109-01091....
速递 | 针对耐药性细菌感染,创新抗生素复方疗法3期临床结果积极
▎药明康德内容团队编辑2021年10月19日,再鼎医药与Entasis Therapeutics宣布,抗生素组合疗法sulbactam-durlobactam(SUL-DUR)在一项3期临床试验获得积极结果。在碳青霉烯类耐药不动杆菌(CRAB)患者中,与多黏菌素相比,SUL-DUR治疗达到统计学意义上的非劣效性标准,与更优的安全性。不动杆菌是一种革兰氏阴性细菌,是一种机会性的人类病原体,主要感染危重患者,通常会导致严重的肺炎和血流感染;但它也可以感染其他身体部位,如泌尿道和皮肤。不动杆菌被认为是一种严重的全球性公共卫生威胁,部分原因是它能够以在其他细菌中以从未见过的速度获得多重耐药性。...
【综述】多重耐药鲍曼不动杆菌肺炎治疗进展
作者:孙康 潘蕾 金发光单位:空军军医大学唐都医院呼吸与危重症医学科;空军特色医学中心呼吸与危重症医学科引用本文: 孙康, 潘蕾, 金发光. 多重耐药鲍曼不动杆菌肺炎治疗进展 [J] . 中华结核和呼吸杂志, 2021, 44(6) : 582-587. DOI: 10.3760/cma.j.cn112147-20201013-01034.摘要近十年来,鲍曼不动杆菌越来越严峻的耐药性已经成为抗感染治疗中面临的严重问题。其固有的和获得性的耐药性,使其对临床大多数抗菌药物不敏感,导致治疗选择非常有限,常常预后不佳。目前缺乏大样本的临床有效数据来指导多重耐药鲍曼不动杆菌感染的最佳治疗方法的选择,尤其是肺炎。本文对近年来有关多重耐药鲍曼不动杆菌肺炎治疗的最新进展、正在研究的新型药物以及有前景的非抗菌药物疗法做一综述。...